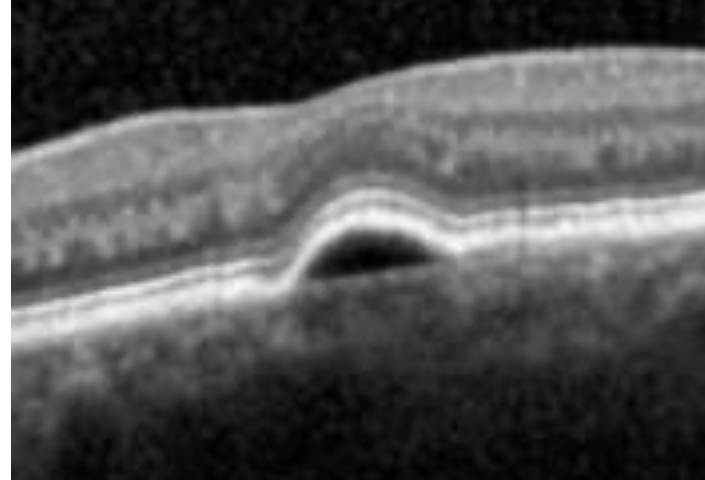
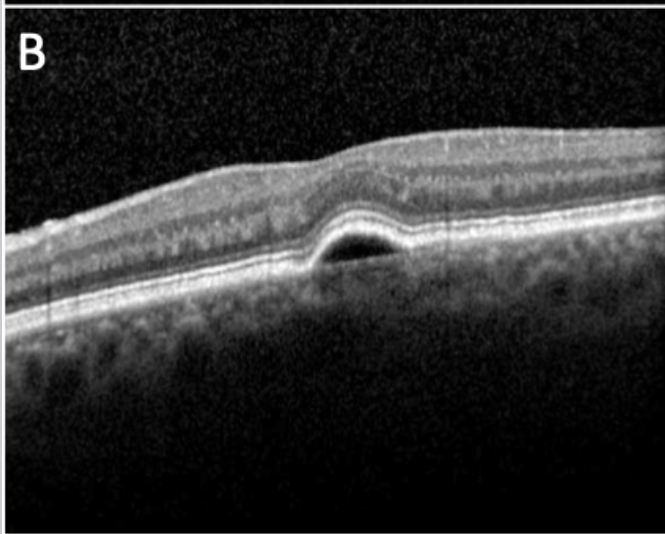
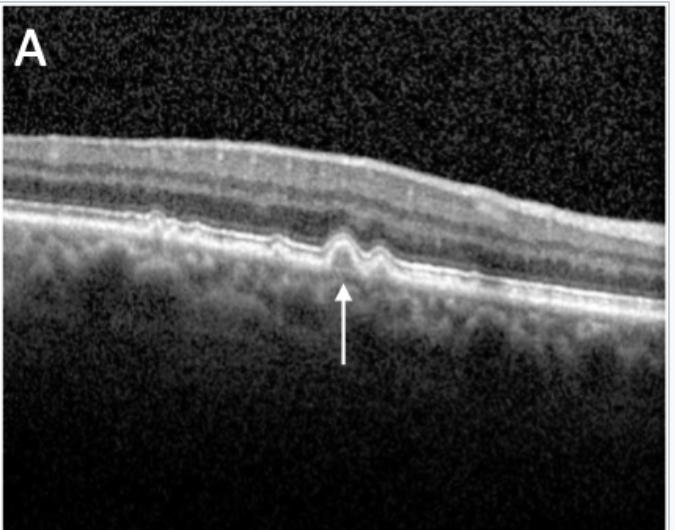

What is early AMD?
- Dry changes (soft drusen, hyper and hypo pigmentation of RPE)
What is late AMD?
- Either: End stage dry AMD (geographic atrophy) or presence of
neovascular AMD
AREDS classification of AMD

Risk factors of AMD

why do we get drusen?
1.damage to photoreceptor by oxidative stress
RPE cells force out unwanted or damaged proteins or lipids that can accumulate in brutes membrane
What is drusen?
abnormal lipid deposits generated by photoreceptors.
between the basal lamina of the RPE and the inner collagenous layer of Bruch’s membrane
pale yellow
What causes Dry AMD?
What are the symptoms of Dry AMD?
-gradual impairment of vision
-later stages:
+ve scotoma
difficulty recognising faces
-difficulty seeing in dim light
painless
What are the signs of Dry AMD?
hard/soft drusen
focal hypo/hyper pigmentation of RPE
geographic atrophy
drusenoid rpe detachment (later stages ^)
What are the differences between hard and soft drusen?
hard:
- small yellow/white spots
-part of normal age processing of eye
-less than half retinal vein width
soft
thickening of Bruch’s membrane
-Larger in size, may coalesce to form confluent drusen ( >125 micron)
Can form drusenoid pigment epithelium detachment
-should be monitored
soft drusen
hard drusen
what is hyper pigmentation?
image
RPE cell proliferationRPE cell migration
Increase in melanin in RPE cells
What is hypopigmentation?
image
seen as small patches of mottled pigment RPE layer thinning
RPE cell atrophy
Reduction in melanin in RPE cells
What is Geographic atrophy ?
1.atrophic areas enlarge and coalesce
2. underlying choroidal vasculature becomes visible
- Advanced GA: visible scleral tissue, loss of drusen,
severe central vision impairment
What is the prognosis or Dry AMD
➢Visual loss is gradual
- Can take approx 10 years to reduce to 6/60 vision or less
*
Central visual loss only – peripheral vision remains intact - Can try and develop eccentric viewing
- Try low vision aids
What is the differential diagnosis of Dry AMD?
- Myopic degeneration
- CSCR
- Toxic retinopathies
(chloroquine,bulls eye macuopathy - Inflammatory maculopathies ( choroiditis, rubella)
How is Wet AMD caused?
What are the symptoms of Wet AMD?
What are the signs of Wet AMD?
What is this?
Pigment epithelium detachment (PED)- when RPE is separated from bucks membrane
on an OCT it looks like a dome shaped elevation of the RPE
Why do we get PED?
serous pd
Orange/pale dome-shaped elevated lesion of
variable size
- Smooth contours, sharply delineated edges
- Hypo-fluorescence on OCT
transilluminate if filled with serous fluid
drusenoid ped
hyper reflective red
often seen in Dry AMD due to confluent drusen
Drusenoid PEDs appear as yellow or yellow–white elevations of the RPE that are usually found within the macula. They may have scalloped borders and a slightly irregular surface









